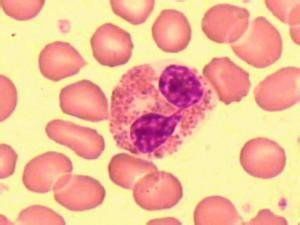
外陰顆粒性肌母細胞瘤 外陰顆粒性肌母細胞瘤

概述
外陰顆粒性肌細胞瘤是一種生長緩慢的良性腫瘤可能來源於神經組織良性腫瘤,為罕見的腫瘤,可侵犯舌皮膚和其他部位包括上呼吸道、消化道和骨骼肌等,多見於陰唇處偶見於陰蒂。
是由什麼原因引起的
發病原因
電鏡已證實瘤細胞源於神經鞘細胞的變形關於其組織發生曾有過多種理論以前認為是由成熟橫紋肌退行性變而成接著又考慮其由不成熟的橫紋肌而來後來又有學者認為是由組織細胞或成纖維細胞而來
發病機制
腫瘤多位於大陰唇生長緩慢局部呈結節狀隆起多呈單個腫塊直徑0.5~3cm一般有較寬的基底質地較堅韌切面無包膜邊界清楚質地均勻切面呈淡黃色或灰黃色有光澤
顯微鏡檢查見瘤細胞集合成粗條索狀或巢狀為細纖維分隔細胞大多角形邊界不清胞質豐富含有明顯的細伊紅色顆粒核或大或小位於中央核仁清晰細胞質顆粒經特殊染色說明並非黏液也不是糖原但蘇丹黑B為陽性PAS染色經酶消化後仍為陽性說明很有可能是糖蛋白並有類脂物這一點支持其神經源性的組織來源學說
有哪些表現及如何診斷
一般無特異的症狀有時患者偶然發現外陰部的腫塊生長緩慢無壓痛生長在外陰部的腫瘤多發於大陰唇的組織深部
婦科檢查時發現外陰部的腫塊質地中等常為單個有時為多個無壓痛
質地較韌直徑小於1cm的小包塊偶有多發性結節表面皮膚有時有色素減退可侵犯外陰及身體他處
根據病史特徵以及組織活檢可確診單個一般為良性多個應警惕惡變
有哪些表現及如何診斷
一般無特異的症狀有時患者偶然發現外陰部的腫塊生長緩慢無壓痛生長在外陰部的腫瘤多發於大陰唇的組織深部
婦科檢查時發現外陰部的腫塊質地中等常為單個有時為多個無壓痛
質地較韌直徑小於1cm的小包塊偶有多發性結節表麵皮膚有時有色素減退可侵犯外陰及身體他處
根據病史特徵以及組織活檢可確診單個一般為良性多個應警惕惡變
可以並發哪些疾病
呼吸道同時患顆粒性肌母細胞瘤
應該如何預防
為預防惡變應行大範圍手術切除術後做好隨訪工作
應該如何治療
治療
治療的原則是要有足夠的手術切除範圍此瘤雖為良性但此種腫瘤沒有包膜粒性成肌細胞瘤具有向周圍組織的延伸浸潤的特性如手術不徹底可復發故較廣泛的女陰切除是必要的但不需做淋巴結清除術在切除標本邊緣應做仔細的檢查如切緣病變存在則需再擴大手術切除範圍
因外陰顆粒性肌母細胞瘤對放射治療不敏感即使復發也只有再次手術經多次手術治療一般預後良好對偶有惡變者應按外陰癌治療處理
預後
一般預後好如手術未切淨有復發可能醫學疾病任務——婦科
| 婦科是醫療機構的一個診療科目,是婦產科的一個分支專業,是以診療女性婦科病為診療的專業科室。女性生殖系統所患的疾病才叫婦科疾病。婦科疾病的種類可分很多種,本任務包含大多數婦科疾病。 |